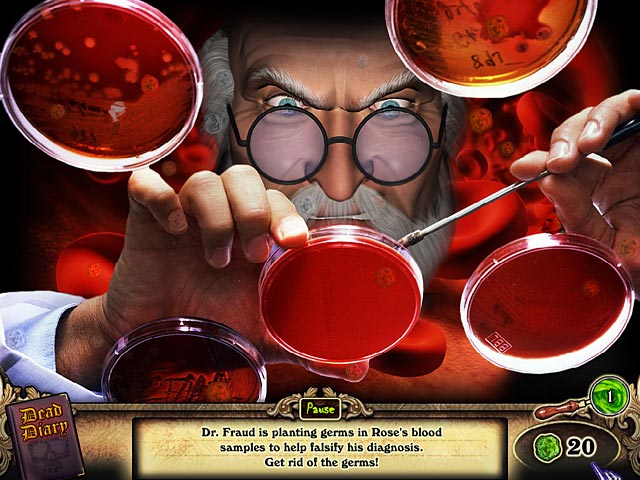

Загрузка...
Redrum
Добро пожаловать в Redrum — игру, где «я ищу» превращается в «я ищу улики, пока не сойду с ума окончательно». Если вы думали, что ваша работа стрессовая, подождите, пока не попробуете быть Роуз — девушкой, которая видит призраков убитых и вынуждена разгадывать их тайны из стен психиатрической лечебницы. Да-да, это не очередной хоррор про заброшенные дома и скачущих маньяков, а уникальный микс психологического триллера и классического квеста в жанре «поиск предметов». Только представьте: вместо того чтобы искать ключи от квартиры, вам предстоит находить улики, которые помогут остановить настоящего врача-маньяка. И все это под пристальным взглядом… ну, скажем так, очень заинтересованных наблюдателей из потустороннего мира.
Redrum — это не просто казуальная игра или инди-проект, а настоящий мозговой штурм в мрачной, но невероятно атмосферной упаковке. Вас ждет череда запутанных дел об убийствах, где каждый призрак — это новая глава в детективе, написанном самой Смертью. Геймплей построен на классических механиках «найди предмет», но с изюминкой: найденные вещи не просто пополняют ваш инвентарь, а раскрывают новые грани сюжета, помогают общаться с духами и постепенно распутывают клубок лжи и безумия. Это как «Шестое чувство» встретилось с «Секретными материалами», а потом решило поиграть в «Скрытые объекты» на сложном уровне. И да, название игры — это не опечатка, а намёк для внимательных зрителей фильма «Сияние». Угадайте, какой?
Особенности Redrum делают её must-play для всех фанатов психологических хорроров и приключенческих игр. Вас ждут:
- Мрачная, но глубоко продуманная история, где каждая деталь имеет значение.
- Атмосфера постоянного напряжения, созданная за счет визуальных экспериментов и реалистичной подачи.
- Уникальный геймплей, сочетающий поиск предметов, решение головоломок и диалоги с потусторонними сущностями.
- Роль Роуз, чьи способности — благословение и проклятие одновременно, запертой в лечебнице, но способной менять ход расследований за её стенами.
Игра идеально подойдет тем, кто устал от шаблонных хорроров и хочет чего-то интеллектуального, но при этом жутко атмосферного. Отзывы игроков часто отмечают, что Redrum — это не просто «еще одна игра про привидения», а продуманное повествование, которое заставляет вас чувствовать себя настоящим детективом, разбирающимся в самых темных уголках человеческой психики.
Так что если вы готовы проверить свою наблюдательность, логику и нервы на прочность, смело погружайтесь в мир Redrum. Ведь кто, как не вы, сможет помочь неупокоенным душам обрести покой и остановить злодеяния маньяка, который считает, что лечит своих пациентов? Главное — не перепутайте реальность с кошмаром. А если вдруг услышите шепот за спиной… ну, вы же знаете, что делать. Удачи в расследовании, детектив!